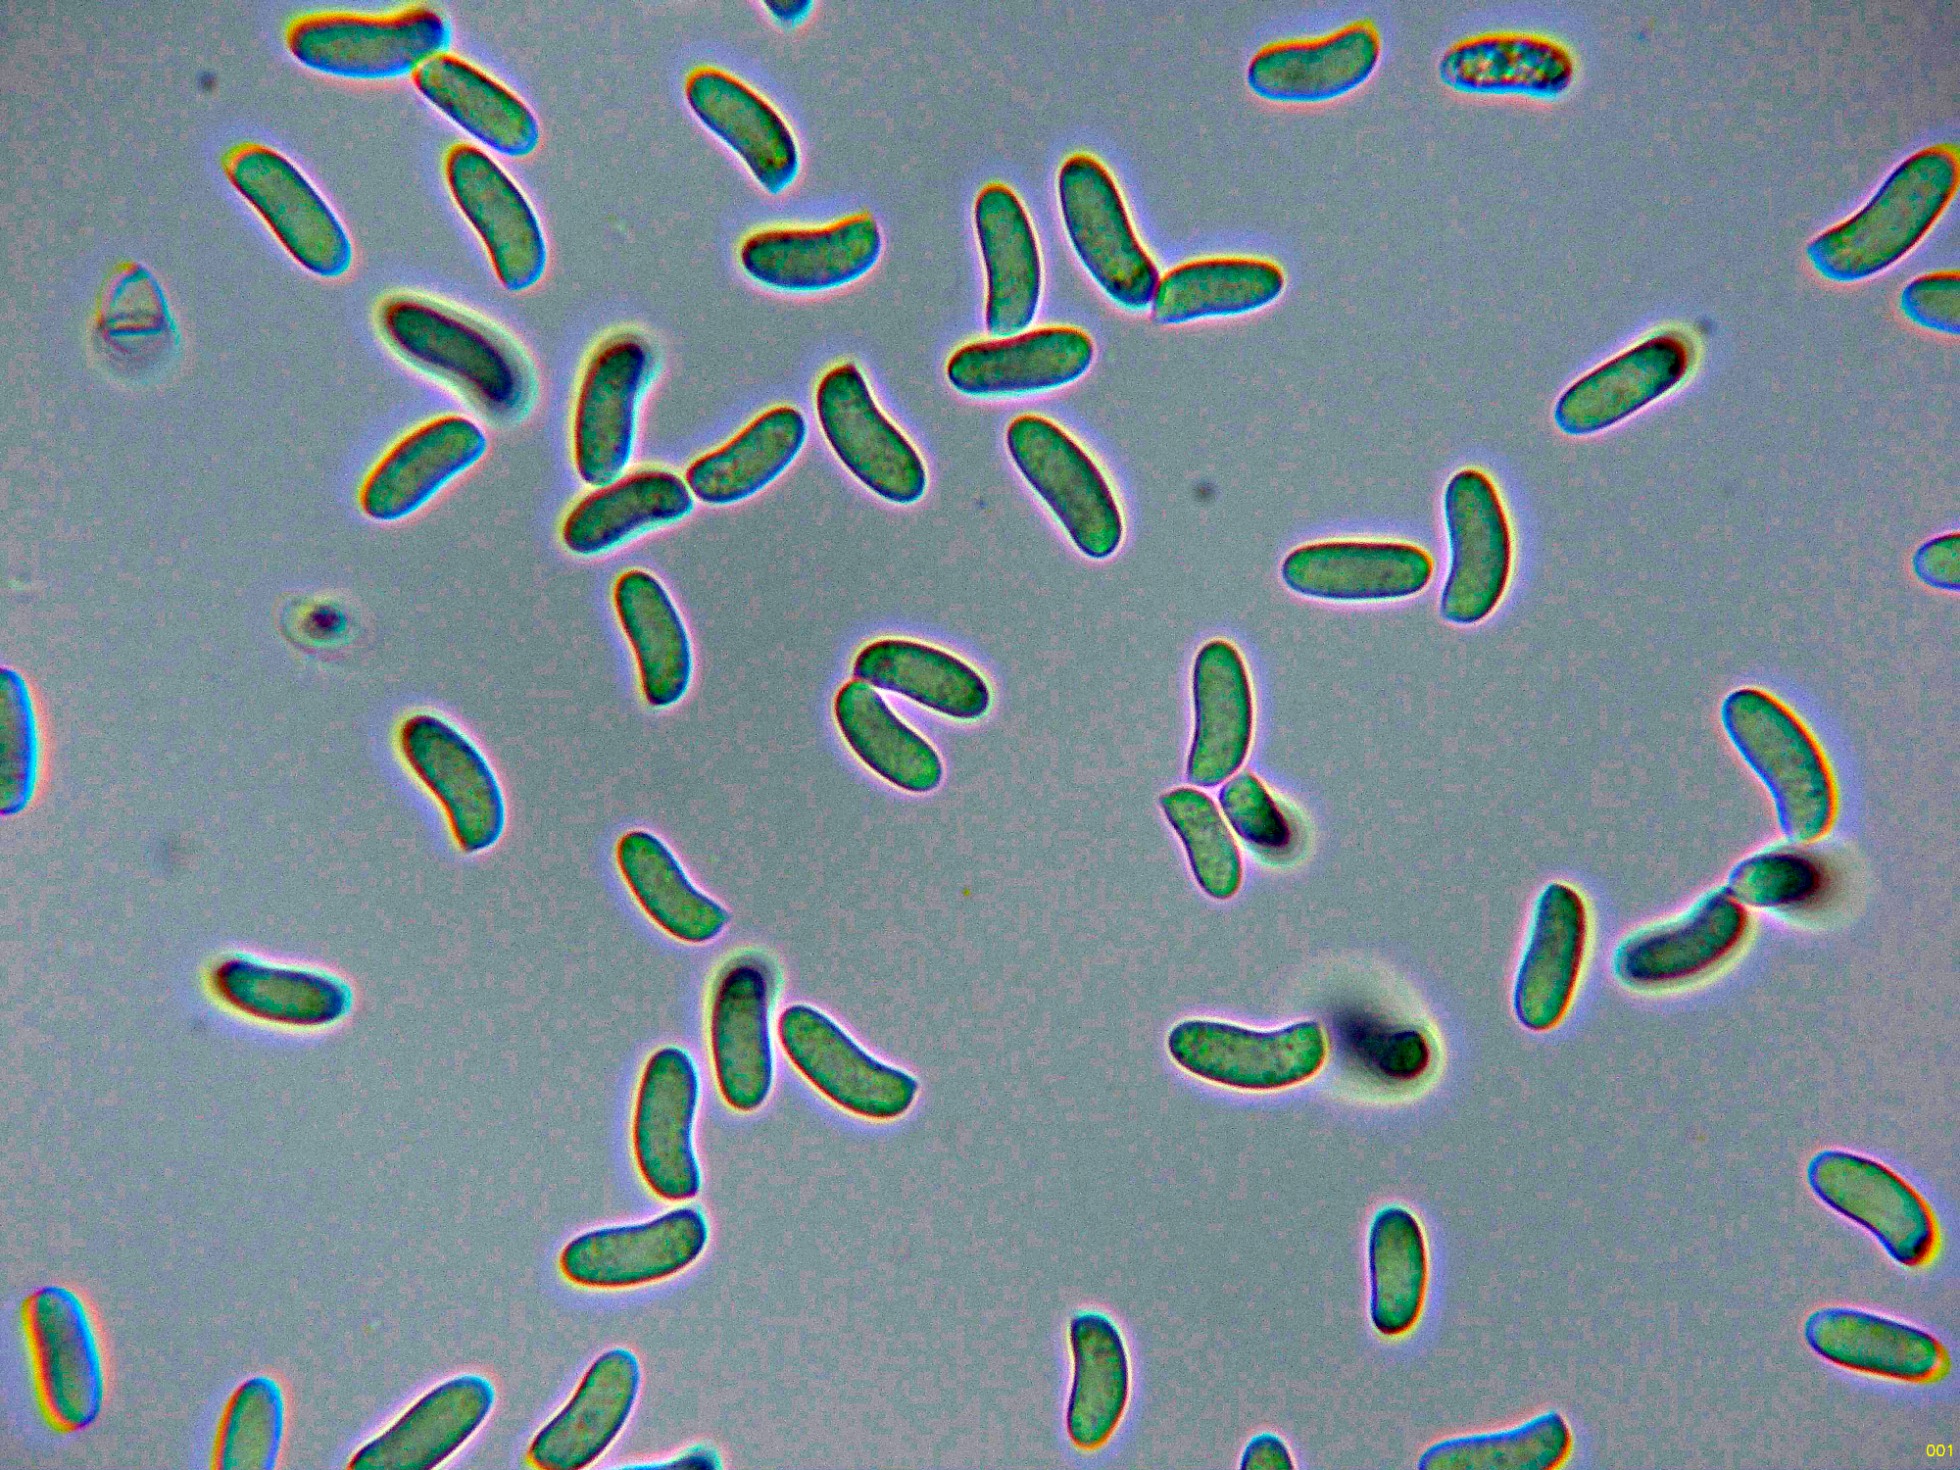

- Foro
- Foros sobre Micología de fungipedia
- Microscopía
- Tomentella stuposa y un par más del domingo 21 de abril.
 Tomentella stuposa y un par más del domingo 21 de abril.
Tomentella stuposa y un par más del domingo 21 de abril.
- Josep Torres
-
 Autor del tema
Autor del tema
- Fuera de línea
- Moderador
-

Menos
Más
- Mensajes: 8746
- Gracias recibidas: 8379
1 año 9 meses antes #110021
por Josep Torres
Hola a tod@s.
Un resto de lo que dio de si la recogida de muestras del domingo 21 de abril pasado.
El primero una Tomentella, segunda vez que me la encuentro, con hifas subiculares fibuladas, sin reacción de sus basidios frente al KOH, con esporas regulares provistas de largas espinas, la Tomentella stuposa.
Un par de ampliaciones de los basidiomas a 20 aumentos.
Las hifas subiculares en Rojo Congo diluido.
Las hifas subiculares en Reactivo de Melzer.
Los basidios en solución de Rojo Congo.
Los basidios en solución de KOH, sin ninguna reacción aparente (hialinos).
Esporas en KOH.
Esporas en Reactivo de Melzer, con el aparato apical inamiloide.
Las esporas en Rojo Congo.
Estas esporas con unas medidas sin contar las espinas de:
(8.2) 8.5 - 10.1 (10.4) × (7.8) 8.2 - 10 µm
Q = 1 - 1.07 (1.1) ; N = 20
Me = 9.5 × 9.2 µm ; Qe = 1
Y ya por último una imágen con las medidas de las espinas, según las claves de hasta 2,5 µm.
Muy parecida a su congénere la Tomentella bryophila, bastante más común y con aparato apical amiloide.
Seguimos con una Peniophora, muy común por los lugares por donde me muevo, la Peniophora lycii.
Una ampliación de la superficie a 20 aumentos.
Los cistidios.
A destacar como característica, las abundantes hifas dendroides en el himenio.
Los basidios.
Y ya por último las esporas en agua.
Estas esporas obtenidas por esporulación natural y en agua, con unas medidas de:
(9) 9.6 - 11.1 (11.8) × (3.6) 3.7 - 4.1 (4.2) µm
Q = (2.3) 2.5 - 2.8 (2.9) ; N = 30
Me = 10.4 × 3.9 µm ; Qe = 2.6
Y ya sin micro, todo un clásico de soto fluvial, la típica seta de chopo, Cyclocybe cylyndracea = Cyclocybe aegerita.
Saludos a tod@s.
Un resto de lo que dio de si la recogida de muestras del domingo 21 de abril pasado.
El primero una Tomentella, segunda vez que me la encuentro, con hifas subiculares fibuladas, sin reacción de sus basidios frente al KOH, con esporas regulares provistas de largas espinas, la Tomentella stuposa.
Un par de ampliaciones de los basidiomas a 20 aumentos.
Las hifas subiculares en Rojo Congo diluido.
Las hifas subiculares en Reactivo de Melzer.
Los basidios en solución de Rojo Congo.
Los basidios en solución de KOH, sin ninguna reacción aparente (hialinos).
Esporas en KOH.
Esporas en Reactivo de Melzer, con el aparato apical inamiloide.
Las esporas en Rojo Congo.
Estas esporas con unas medidas sin contar las espinas de:
(8.2) 8.5 - 10.1 (10.4) × (7.8) 8.2 - 10 µm
Q = 1 - 1.07 (1.1) ; N = 20
Me = 9.5 × 9.2 µm ; Qe = 1
Y ya por último una imágen con las medidas de las espinas, según las claves de hasta 2,5 µm.
Muy parecida a su congénere la Tomentella bryophila, bastante más común y con aparato apical amiloide.
Seguimos con una Peniophora, muy común por los lugares por donde me muevo, la Peniophora lycii.
Una ampliación de la superficie a 20 aumentos.
Los cistidios.
A destacar como característica, las abundantes hifas dendroides en el himenio.
Los basidios.
Y ya por último las esporas en agua.
Estas esporas obtenidas por esporulación natural y en agua, con unas medidas de:
(9) 9.6 - 11.1 (11.8) × (3.6) 3.7 - 4.1 (4.2) µm
Q = (2.3) 2.5 - 2.8 (2.9) ; N = 30
Me = 10.4 × 3.9 µm ; Qe = 2.6
Y ya sin micro, todo un clásico de soto fluvial, la típica seta de chopo, Cyclocybe cylyndracea = Cyclocybe aegerita.
Saludos a tod@s.
Adjuntos:
El siguiente usuario dijo gracias: Juan Andrés Román
Por favor, Identificarse para unirse a la conversación.
- Juan Andrés Román
-

- Fuera de línea
- Spammer
-

Menos
Más
- Mensajes: 2558
- Gracias recibidas: 2756
1 año 9 meses antes #110030
por Juan Andrés Román
Respuesta de Juan Andrés Román sobre el tema Tomentella stuposa y un par más del domingo 21 de abril.
Buena minitacada Josep.............................. Saludos.
El siguiente usuario dijo gracias: Josep Torres
Por favor, Identificarse para unirse a la conversación.
- Foro
- Foros sobre Micología de fungipedia
- Microscopía
- Tomentella stuposa y un par más del domingo 21 de abril.
Tiempo de carga de la página: 0.199 segundos

Foro de micología